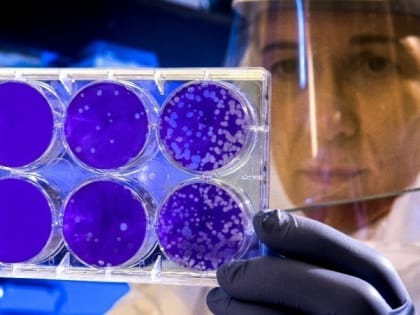
В России выявили второй случай заболевания «кракеном»

Здоровье

В Астрахани во Всемирный день борьбы против рака пройдёт акция
Рак — это злокачественная опухоль, которая может нарушить все ваши планы и поразить любую часть тела.

Собакам из астраханского «Экоприюта» нашли новых хозяев
В конце 2022 года в «Экоприюте» произошла вспышка бешенства и чумки.

Онколог клиники им. Наталии Силищевой принял участие в программе ко Дню борьбы с раком
Всемирный день борьбы против рака — памятная дата, отмечаемая ежегодно 4 февраля .

Астраханцев приглашают бесплатно проверить здоровье
Акция «Суббота для здоровья» приурочена ко Всемирному дню борьбы против рака.
В России выявили второй случай заболевания «кракеном»
Ранее, 12 января, мы рассказывали о первом выявленном в России случае заболевания вариантом коронавируса «кракен».

4 февраля Всемирный День борьбы против рака
Ежегодно 4 февраля отмечается Всемирный День борьбы против рака. Его организатором выступает Союз по международному контролю над раком, который на сегодняшний день объединяет свыше 1,2 тысячи организаций из 172 стран,

В рамках мероприятий, приуроченных ко Всемирному дню борьбы против рака, на базе ГБУЗ АО «Областной центр общественного здоровья и медицинской профилактики» пройдет «День открытых
В ходе акции все желающие без направления смогут пройти комплексное обследование состояния здоровья, получить консультации врачей-специалистов,

Снегопад идет в Астрахань
С 3 по 7 февраля в Астраханской области пасмурно, завтра обещают снег с дождем.

В астраханской детской клинике новорождённым проводят расширенный скрининг
В работу неонатальной службы страны с 1 января была включена программа расширенного скрининга новорождённых.

В Росздравнадзоре заявили о достаточном количестве препаратов в астраханских аптеках
Более 5 млн упаковок препаратов различных наименований имеются в аптеках Астраханской области, что удовлетворяет потребности региона, сообщается в телеграм-канале Росздравнадзора.